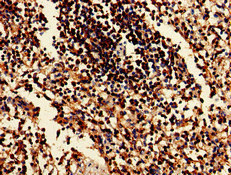

EIF2AK1 Antibody
-
中文名稱:EIF2AK1兔多克隆抗體
-
貨號:CSB-PA007510LA01HU
-
規格:¥440
-
圖片:
-
Western Blot
Positive WB detected in: HepG2 whole cell lysate, A549 whole cell lysate, HEK293 whole cell lysate, Rat heart tissue, Rat lung tissue
All lanes: EIF2AK1 antibody at 3μg/ml
Secondary
Goat polyclonal to rabbit IgG at 1/50000 dilution
Predicted band size: 72 kDa
Observed band size: 72 kDa -
Immunohistochemistry of paraffin-embedded human spleen tissue using CSB-PA007510LA01HU at dilution of 1:100
-
Immunohistochemistry of paraffin-embedded human testis tissue using CSB-PA007510LA01HU at dilution of 1:100
-
Immunofluorescent analysis of HepG2 cells using CSB-PA007510LA01HU at dilution of 1:100 and Alexa Fluor 488-congugated AffiniPure Goat Anti-Rabbit IgG(H+L)
-
-
其他:
產品詳情
-
產品名稱:Rabbit anti-Homo sapiens (Human) EIF2AK1 Polyclonal antibody
-
Uniprot No.:
-
基因名:
-
別名:E2AK1_HUMAN antibody; EC 2.7.11.1 antibody; Eif2ak1 antibody; Eukaryotic translation initiation factor 2 alpha kinase 1 antibody; Eukaryotic translation initiation factor 2-alpha kinase 1 antibody; HCR antibody; Heme controlled repressor antibody; Heme regulated eukaryotic initiation factor eIF 2 alpha kinase antibody; Heme regulated inhibitor antibody; Heme regulated initiation factor 2 alpha kinase antibody; Heme regulated repressor antibody; Heme sensitive initiation factor 2a kinase antibody; Heme-controlled repressor antibody; Heme-regulated eukaryotic initiation factor eIF-2-alpha kinase antibody; Heme-regulated inhibitor antibody; Hemin sensitive initiation factor 2 alpha kinase antibody; Hemin-sensitive initiation factor 2-alpha kinase antibody; HRI antibody; KIAA1369 antibody; PRO1362 antibody
-
宿主:Rabbit
-
反應種屬:Human, Rat
-
免疫原:Recombinant Human Eukaryotic translation initiation factor 2-alpha kinase 1 protein (1-86AA)
-
免疫原種屬:Homo sapiens (Human)
-
標記方式:Non-conjugated
本頁面中的產品,EIF2AK1 Antibody (CSB-PA007510LA01HU),的標記方式是Non-conjugated。對于EIF2AK1 Antibody,我們還提供其他標記。見下表:
-
克隆類型:Polyclonal
-
抗體亞型:IgG
-
純化方式:>95%, Protein G purified
-
濃度:It differs from different batches. Please contact us to confirm it.
-
保存緩沖液:Preservative: 0.03% Proclin 300
Constituents: 50% Glycerol, 0.01M PBS, pH 7.4 -
產品提供形式:Liquid
-
應用范圍:ELISA, WB, IHC, IF
-
推薦稀釋比:
Application Recommended Dilution WB 1:500-1:5000 IHC 1:20-1:200 IF 1:50-1:200 -
Protocols:
-
儲存條件:Upon receipt, store at -20°C or -80°C. Avoid repeated freeze.
-
貨期:Basically, we can dispatch the products out in 1-3 working days after receiving your orders. Delivery time maybe differs from different purchasing way or location, please kindly consult your local distributors for specific delivery time.
-
用途:For Research Use Only. Not for use in diagnostic or therapeutic procedures.
相關產品
靶點詳情
-
功能:Metabolic-stress sensing protein kinase that phosphorylates the alpha subunit of eukaryotic translation initiation factor 2 (EIF2S1/eIF-2-alpha) in response to various stress conditions. Key activator of the integrated stress response (ISR) required for adaptation to various stress, such as heme deficiency, oxidative stress, osmotic shock, mitochondrial dysfunction and heat shock. EIF2S1/eIF-2-alpha phosphorylation in response to stress converts EIF2S1/eIF-2-alpha in a global protein synthesis inhibitor, leading to a global attenuation of cap-dependent translation, while concomitantly initiating the preferential translation of ISR-specific mRNAs, such as the transcriptional activator ATF4, and hence allowing ATF4-mediated reprogramming. Acts as a key sensor of heme-deficiency: in normal conditions, binds hemin via a cysteine thiolate and histidine nitrogenous coordination, leading to inhibit the protein kinase activity. This binding occurs with moderate affinity, allowing it to sense the heme concentration within the cell: heme depletion relieves inhibition and stimulates kinase activity, activating the ISR. Thanks to this unique heme-sensing capacity, plays a crucial role to shut off protein synthesis during acute heme-deficient conditions. In red blood cells (RBCs), controls hemoglobin synthesis ensuring a coordinated regulation of the synthesis of its heme and globin moieties. It thereby plays an essential protective role for RBC survival in anemias of iron deficiency. Similarly, in hepatocytes, involved in heme-mediated translational control of CYP2B and CYP3A and possibly other hepatic P450 cytochromes. May also regulate endoplasmic reticulum (ER) stress during acute heme-deficient conditions. Also activates the ISR in response to mitochondrial dysHRI/EIF2AK1 protein kinase activity is activated upon binding to the processed form of DELE1 (S-DELE1), thereby promoting the ATF4-mediated reprogramming.
-
基因功能參考文獻:
- Activation of HRI is mediated by Hsp90 during stress through modulation of the HRI-Hsp90 complex PMID: 30170366
- Taken together, these results suggest HRI as a potential therapeutic target for hemoglobinopathies. PMID: 30026227
- data suggests that glutamatergic stimulation induces HRI activation by NO to trigger GluN2B expression and this process would be relevant to maintain postsynaptic activity in cortical neurons PMID: 27557499
- The antiviral kinase PKR plays a critical role in controlling HCMV replication. PMID: 27974558
- structural and functional stability of HRI PMID: 27888007
- Infection-associated functions of HRI (an eIF2alpha kinase) are independent of its activity as a regulator of protein synthesis. PMID: 23874749
- During lead-stress, the regulation of hHRI mRNA translation is mediated through its 5'-untranslated region (UTR) that interacts with specific trans-acting factors. PMID: 23357686
- Dephosphorylation of eIF2alpha, specifically in the cortex, is both correlated with and necessary for normal memory consolidation. PMID: 23392680
- eukaryotic initiation factor 2alpha kinase is a protagonist of heme-mediated translational control of CYP2B enzymes and a modulator of basal endoplasmic reticulum stress tone. PMID: 20071449
- autophosphorylation of Thr485 is essential for the hyperphosphorylation and activation of HRI and is required for the acquisition of the eIF2alpha kinase activity PMID: 12767237
- These data establish for the first time, the possible mechanisms of regulation of hHRI gene expression under normal physiological condition, hemin exposure and stress. PMID: 19133234
顯示更多
收起更多
-
蛋白家族:Protein kinase superfamily, Ser/Thr protein kinase family, GCN2 subfamily
-
組織特異性:Expressed predominantly in erythroid cells. Expressed at much lower levels in hepatocytes (at protein level).
-
數據庫鏈接:
Most popular with customers
-
-
YWHAB Recombinant Monoclonal Antibody
Applications: ELISA, WB, IHC, IF, FC
Species Reactivity: Human, Mouse, Rat
-
Phospho-YAP1 (S127) Recombinant Monoclonal Antibody
Applications: ELISA, WB, IHC
Species Reactivity: Human
-
-
-
-
-